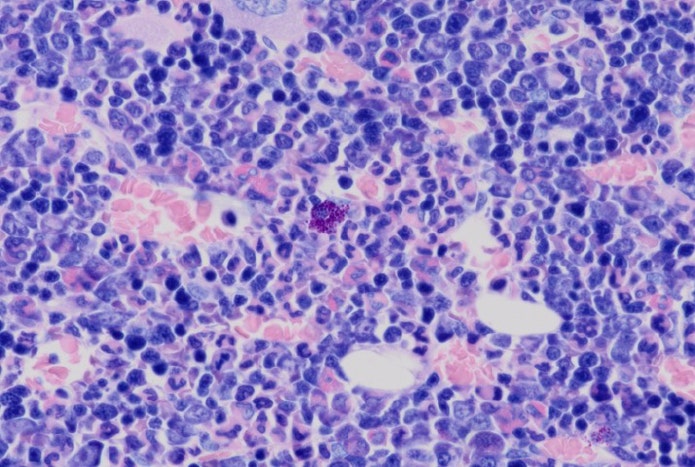
Microscope image of rat bone marrow captured using the DP23 camera.

Meet the Award-Winning DP28 and DP23 Microscope Cameras

Our DP28 and DP23 digital microscopes and imaging systems* were chosen by a committee of clinicians and healthcare professionals to receive a Premier Innovation Award for their potential to meet unmet clinical needs and improve patient care. Here are some of the reasons they were chosen to win such a prestigious award.



The award-winning DP28 (left) and DP23 (right) digital microscope cameras.
Connected for a Changing Lab
The world has changed, and researchers need connected tools that enable them to efficiently work and collaborate outside the lab. The DP28 and DP23 offer advanced connectivity so that all critical imaging data—including images, annotation, and live measurements—can be displayed and shared together locally or remotely using cellSens software with the NetCam solution or the DP standalone camera control module’s remote image sharing function. This provides a simple way to discuss and share full HD, live images with colleagues.

Pig liver captured by the DP28 camera.
The Power for Research or Routine Imaging
Connectivity isn’t helpful if you can’t capture the images you need. We created the DP28 and DP23 cameras to provide the flexibility to choose between a model that offers 4K ultra-high-definition image quality or one with balanced 6.4-megapixel resolution and 45 frames per second (fps) frame rate. And both cameras share the same suite of smart, time-saving features that make them convenient and easy to use.
The cameras offer a wide field of view up to FN25 and produce exceptional color accuracy, critical when working with stained samples. Smart features, like Olympus smart image averaging, which suppresses noise while maintaining a high frame rate and eliminating artifacts to produce clear images, high contrast mode to capture clear images of dim samples, and focus peaking to quickly identify which areas of the sample are in focus, make capturing high-quality images easy.
Rat bone marrow captured by the DP23 camera.
We’re honored that the DP28 and DP23 cameras received a prestigious Premier Innovation Award. Thanks to the clinicians and healthcare professionals who selected the cameras and to our customers for their continued support.
*The cameras are not for clinical diagnostic use.
